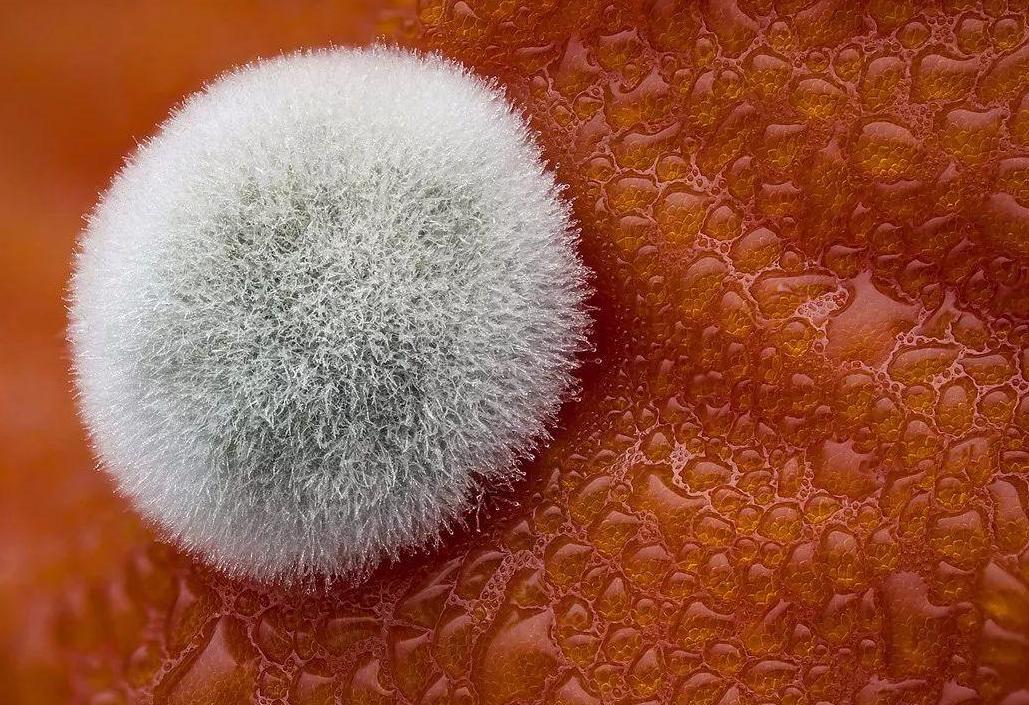
食物发霉削掉还可以再吃吗,食物发霉后切到发霉地方能吃吗

食物有时候会发霉,特别是在潮湿天气里,稍不留神就发霉了。这时候,想必有人的做法是扔掉霉变的部分,剩下没发霉的一部分继续吃掉。那么食物已经发霉了,切掉坏的部分以后还能吃吗?其实肉眼看不见,并不代表真干净,下面我们就一起来看看。

食物发霉介绍
食物霉变原因
霉菌的学名叫白色念珠菌,这是一个大类。首先,想要发霉必须要有霉菌或者其孢子等,这些家伙们几乎存在于自然环境的各处。但为什么真空包装等有时也会发霉?可能是由于杀菌时没杀干净留下孢子等。其次,我们要知道,大多数霉菌大量繁殖的要求是需要水和养分,而往往食物中富含这些东西。因此,食物成了霉菌十分喜爱的“小窝”,它们就在这里疯狂生长了。

简单粗暴的食物霉变预防
那么,该怎样预防食物霉变?其实,对于大多数食品特别是水果来说,最好是“现吃现买”,不仅是为了防止发霉,也是为了新鲜。再者,对于真空包装一类的东西,最好是挑选消毒杀菌合格的,避免购买有漏气等问题的。

食用发霉食物的危害
霉菌自身以及霉菌产物都可能对人身有所损害。吃霉变食物,基本相当于吃“霉菌和它的产物”。吃得少并且菌种毒性很弱或者无毒的,吐出来或者不吐其实可能都没法有什么感觉,最好是摄入后喝点牛奶保护肠胃,及时喝水排泄等等。但如果食用的是黄曲霉等产生剧毒的霉菌,那就不好说了。目前的研究表明,黄曲霉素在1毫克每千克即可诱发癌症。食用有毒发霉食物,由于化学毒素还可能导致食物中毒。比如肠胃炎,严重腹泻甚至晕厥等。

霉变食物中“看起来没发霉”的地方为何不能吃
人眼之所以可以看出发霉的部位,主要是因为发霉部位的霉菌等极多。而霉菌是会扩散的,通常来说,那些看起来没发霉的部分也有了较多霉菌及其产物,只是暂时数量达不到肉眼可见的地步。部分味觉灵敏的人可以尝出来这部分的味道也有股霉味儿。所以,霉变食物没发霉的部位也是有霉菌的,能不吃就不吃。不能因为肉眼看不到发霉,就觉得是干净的。

有的人会觉得,高温加热杀死没霉变部位的霉菌,就可以吃了。这种做法对于大多数霉菌是不起作用的。就算霉菌能被完全杀死,它们分泌的物质也无法消除,而且它们的孢子一般十分耐热耐寒,普通加热基本拿他们毫无办法。所以,对于霉变的食物,最好还是整个扔了吧。

不仅如此,由上述我们也可以知道,有的物品发霉初期我们是看不出来的,因此,食物最好在保质期内吃完,水果海鲜等最好不要长时间冷冻,现用现买等。

如何判断霉变
首先,根据食物的外观来判断。这个方法十分容易,大部分霉菌大面积聚集之后是十分明显的。对于食物来说,发霉的特点有食物上有蓝色,绿色,红色等等颜色的斑点,有酸馊气味,触摸发粘等。

其次,根据食物的气味。对于怀疑霉变的食物,最好不要轻易品尝,可以闻一闻气味,是不是有股霉味儿。当然,这种方法比较适用于紧靠外观无法判断的情况,因为霉菌对呼吸道黏膜也是会有损害的。
常见霉菌
首先就是大名鼎鼎的黄曲霉了,这种产生强烈毒物黄曲霉素的菌往往喜欢生活在淀粉含量高的地方,包括但不限于食物。而对于食物,它又喜欢谷物,坚果,玉米油,花生油等等地方,大家要格外注意。

此外,常见的菌种还有扩展青霉菌,曲霉菌等等。
当然,有的霉菌也是有它的好处的,青霉素等抗生素即为从霉菌种提取出来的,制作腐乳等也需要用到毛霉等霉菌。

总结
其实,不仅食物会发霉,土壤,种子,甚至木桌子都有可能发霉,接触霉菌后及时洗手消毒,同时也要避免吸入过多霉菌及其产物。所以,霉变的食物看起来没发霉的部位最好还是别吃。
#清风计划# #超能健康团#
本文由百姓医生原创,欢迎关注,带你一起长知识!